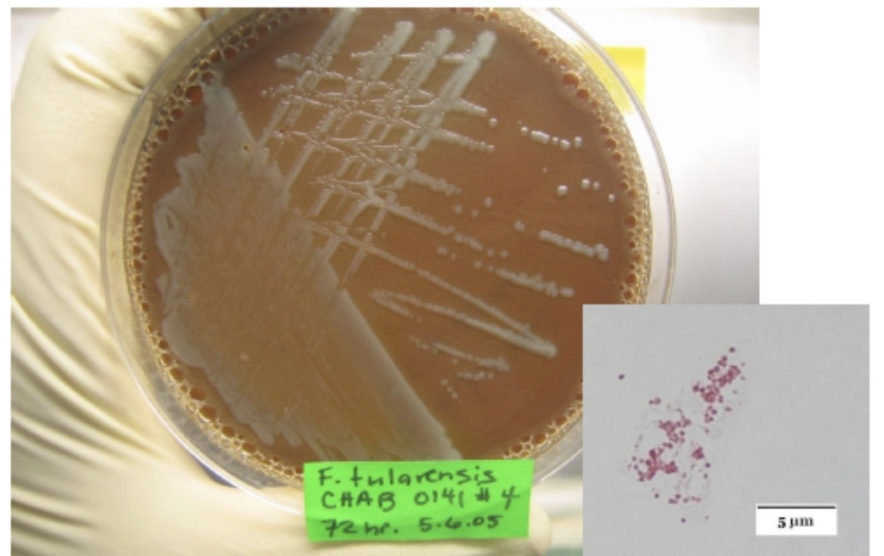

With the reported rise of mutants with increased transmissibility and potential immune escape supported by epidemiological and clinical data, the search for a panacea which will cover all strains of SARS-CoV-2 has become a frenzied pursuit. Such haste and grasping any favorable observations, no matter how tenuous, have inundated social media, the press, and placed undue pressure on medical institutions to modify and scale back their warnings about such unsubstantiated treatments and prophylactics, https://www.nytimes.com/interactive/2021/health/coronavirus-mutations-B117-variant.html. The problem is balancing the specific with the non-specific. The former decreases adverse side effects, such as anaphylaxis and Guillain-Barré syndrome (GBS; neurological weakness and paralysis), but is subject to mutation leading to neutralization of effectiveness. The 1976 flu vaccine, I took while in the military and which was falsely associated with GBS, rose public concern and misconceptions and fears because of a historic small increase in GBS risk associated with the vaccine, which was later found to be lower than initially thought. Concerns about vaccine-related GBS risk persist despite comprehensive surveillance of influenza vaccine-related increases showing only one additional case of GBS per million flu vaccinations. In contrast, the risk of flu-related complications is 17 per million cases. A recent study showed no link between COVID-19 and Guillain-Barré syndrome https://www.cidrap.umn.edu/news-perspective/2020/12/study-finds-no-link-between-covid-19-guillain-barr-syndrome and https://academic.oup.com/brain/advance-article/doi/10.1093/brain/awaa433/6031905. The most common trigger for GBS is infection with Campylobacter jejuni, a bacterium that causes gastroenteritis, or infection of the digestive tract, the most common cause of food borne illness. Therefore, benefits of vaccination far outweigh the risks. The use of broad spectrum, non-specific potential treatments have more adverse side effects associated with them, and diluted effectiveness.
What are we up against? Three mutants V367F, W436R, and D364Y, have arisen in Wuhan, Shenzhen, Hong Kong, and France, which have demonstrated higher human ACE2 affinity. This is because of enhanced stabilization of the receptor binding protein (receptor binding domain, RBD). High frequencies of RBD mutations have been identified: V367F with five mutations from France and one Hong Kong mutant, V483A, and G476S mutant from the USA. Lineage B.1.1.7 (also called 501Y.V1) is rapidly spreading in southeastern England. It has 17 mutations which developed prior to its detection in early September 2020, which indicates prior evolution, possibly in a chronically infected patient. B.1.1.7 expanded when SARS-CoV-2 cases were widespread and achieved dominance by outcompeting an existing population of circulating virus, natural selection of virus more transmissible. Dr. Joel Ernst, an infectious disease expert at UCSF, has stated the B.1.1.7 UK variant has been found in 22 states so far, including 72 cases in California, according to the Centers for Disease Control and Prevention.
The variant in South Africa was first detected in Nelson Mandela Bay in samples dating back to the beginning of October 2020. South Africa showed a sharp rise in the number of infected during November 2020, and reported 501Y.V2 to the World Health Organization on 18 Dec 2020. More than 1.3 million people have been infected with the virus in South Africa, highest of any African nation, more than 37,000 South Africans have died from COVID-19. Most new infections are caused by the 501Y.V2 variant.
Mutations have significantly changed the South African virus’ spike protein; the spike protein has now rotated about twenty degrees and can therefore get more deeply into the binding site on cells; thus, the virus can bind better to human cells, enabling it to become a more efficient virus for transmission. The South Africa variant is about 50% more contagious than the original strain. The Western Cape region took 107 days to reach 100,000 cases in the first wave compared to 54 days in the second wave, when the variant appeared. The South African variant has spread to 14 countries. The director of the Centers for Disease Control and Prevention said, 29 Jan 2021, that the South African Covid-19 variant, which was just detected in two people in South Carolina, had already reached the point of community spread in the U.S. On 9 Jan 2021, Japan notified WHO of a new SARS-CoV-2 variant B.1.1.28 detected in 4 travelers from Brazil. This variant has 12 mutations to the spike protein, including 3 mutations in common with 501Y.V2, ie, K417N/T, E484K and N501Y, which potentially can change transmissibility and host immune responses. Brazil has also reported emergence of a similar variant, with E484K mutation, which evolved independently of the variant from the travelers.
By mid January 2021, Dr. Charles Chiu, director of the UCSF-Abbott Viral Diagnostics and Discovery Center, from sequencing results from his lab at UCSF, found a rare variant, that Chiu had only seen in a handful of samples, suddenly jump up to 25% in his samples. Chiu’s team was the first to report the new variant, now called L452R, but within days, diagnosticians at Cedars-Sinai reported the same variant was now making up more than a third of cases in Los Angeles.
Now Delta (B.1.617.2) variant is currently the most prevalent variant in the United States. New data indicate that the Delta variant spreads almost twice as fast as the original SARS-CoV-2 virus.
These variants suggest specific antiviral measures may be sidestepped by their changes if the measures are targeted too specifically to an antigen. I stated this in an earlier post about monoclonal antibody driving escape mutations by selection pressure. This has been borne out by recent clinical studies. Treatment with bamlanivimab and etesevimab, monoclonal anti-spike antibodies to different epitope targets, of nonhospitalized patients with mild to moderate COVID-19 illness, compared with placebo, showed statistically significant decrease in SARS-CoV-2 viral load at day 11; however, no significant reduction in viral load was seen with bamlanivimab monotherapy. The South African strain has also demonstrated escape from such treatment. It has been observed to completely escape from three monoclonal antibodies, reported by scientists from three South African universities, with the National Institute for Communicable Diseases (NICD), in a paper published on the bioRxiv website (https://bit.ly/2Y0lHEt). In addition, 501Y.V2 showed substantial or complete escape from neutralizing antibodies from COVID-19 convalescent plasma. They concluded reinfection could occur, and the differences in the variant may lead to reduced efficacy of current spike-based vaccines (New COVID-19 Variant Defeats Plasma Treatment, MABs, May Reduce Vaccine Efficacy – Medscape – Jan 20, 2021). Such dire predictions, have led individuals and physicians to pursue broad-spectrum treatments which make such variations irrelevant.
Didier Raoult’s tarnished claim hydroxychloroquine and azithromycin were effective against COVID-19 has not completely died because of this need for a generalized treatment, even in the scientific community. In a recent ACS paper, the investigators used hydroxychloroquine (HCQ) as a reference template to screen for structural similarity against a library of approximately 4000 approved drugs. The top-ranked drugs, based on structural similarity to HCQ, selected for in vitro antiviral assessment, were zuclopenthixol and nebivolol, which blocked SARS-CoV-2 in vitro infection with EC50 values in the low micromolar range. The anti-SARS-CoV-2 potential of ambroxol, amodiaquine, and its active metabolite (N-monodesethyl amodiaquine) were discussed. They concluded both the pKa (acidity) and the HCQ aromatic core play a role in antiviral activity. These are such broad mechanisms that such studies are academic and may have too many in vivo variable interactions to be clinically relevant (Giovanni Bocci et al. ACS Pharmacol. Transl. Sci. 2020, 3, 6, 1278–1292; publication date: October 14, 2020, https://doi.org/10.1021/acsptsci.0c00131). Unfortunately, another anti-parasitic drug, Ivermectin, has been revisited as a general antiviral after 50 years of study that have not translated into such clinical use https://www.ncbi.nlm.nih.gov/pmc/articles/PMC7251046/pdf/210_2020_Article_1902.pdf and https://www.nature.com/articles/s41429-020-0336-z.pdf. Among the many mechanisms of action of Ivermectin, the most relevant to antiviral activity is as an inhibitor of nuclear transport mediated by the importin α/β1 heterodimer, responsible for the translocation of various viral species proteins. Unfortunately, most of the viruses it is supposed to effect are not inhibited in replication or infection, or at least consistently. For HIV type 1, a study showed that Ivermectin failed to control the nuclear accumulation of telomer repeat factor-1 (GFP-TRF) which can only be transferred by IMPβ1 to the cell nucleus disputing the proposed mechanism. Researchers concluded that Ivermectin is not a specific inhibitor for IN-IMP α/β interaction, but it appears to be a specific inhibitor of cargos that are dependent on the heterodimer, making its predicted antiviral activity in a host even more suspicious. Law of diminishing returns seems to come into play with Ivermectin treatment. Virus out runs capacity. In pigs with circovirus 2, in the first 24 hrs, Ivermectin reduced viral load by 41% and 28.2%, However, in 48 hrs, it reduced viral load 28.8% and 15.7%, at the same treatment concentrations. Evidently, it decreases in drug efficacy at later time points of infection. In a recent study among adults with mild COVID-19, a 5-day course of ivermectin, compared with placebo, did not significantly improve the time to resolution of symptoms. The findings did not support the use of ivermectin for treatment of mild COVID-19 https://jamanetwork.com/journals/jama/articlepdf/2777389/jama_lpezmedina_2021_oi_210022_1614808764.76432.pdf. In spite of all its years of use in Veterinary Medicine, to prevent heartworms in dogs and other worms in livestock, I have never heard of a veterinarian using it to treat viral infections. Also, I don’t see Ivermectin listed in the Overview of Antiviral Agents, Pharmacology, in the Merck Veterinary Manual. For Ivermectin to be effective against SARS-CoV-2, in cell culture, the concentrations had to be in the microgram per ml range, blood levels of Ivermectin are at safe therapeutic doses in the 20–80 ng/ml range.
The National Institutes of Health (NIH), under pressure from clinicians, has dropped its recommendation against the inexpensive antiparasitic drug Ivermectin for treatment of COVID-19, and the agency now states it can’t recommend for or against its use, leaving the decision to physicians and their patients. “Results from adequately powered, well-designed, and well-conducted clinical trials are needed to provide more specific, evidence-based guidance on the role of ivermectin for the treatment of COVID-19,” according to new NIH guidance released recently. Some clinical studies showed no benefits or worsening of disease after its use; however, others reported shorter time to resolution of disease. This may be tied to viral load or just an unreliable, unpredictable response.
Some have already failed clinical trials (such as hydroxychloroquine) and some seem counterintuitive (like the immunosuppressant cyclosporine) so caution must be taken in extrapolating these results and they only be considered for suggesting possible clinical testing candidates. They found nine drugs with antiviral activity in lung epithelial cells: 7 of the drugs have been used in humans, 3 FDA approved in the United States (cyclosporine, dacomitinib, and salinomycin), and ebastine (an anti-histamine) approved outside the United States (https://www.cell.com/action/showPdf?pii=S2211-1247%2821%2900273-4). Some of the immunosuppressive and ant-histamine anti-SARS-CoV-2 activities may be explained by the linkage of the host response to the virus to the peculiar anti-parasite, anti-tumor immunity and its adverse effects in COVID.
Other non-immune-mediated drugs are being considered. The government is paying Merck & Co about 356 million USD to fast-track production of one of its potential treatments under Operation Warp Speed. The funding will allow the company to deliver up to 100,000 doses by 30 June 2021, if successful and FDA clears the treatment for emergency use. It is called MK-7110, designed to minimize damaging effects of an overactive immune response to COVID-19. Another promising drug is plitidepsin (aplidin), 27.5 times more potent than remdesivir in cell culture. The mechanism of action against SARS-CoV-2 is through inhibiting eEF1A, a key cellular protein in proliferation and growth (the eukaryotic elongation factor 1 α, eEF1A). During protein translation, eEF1A recruits aminoacyl t-RNA to the ribosome and translocates the growing polypeptide from the ribosomal A site to the P site. Therefore, the drug inhibits viral protein production and, subsequently, viral replication. It’s potential toxicity, because of this non-specificity, is on protein synthesis, growth and healing. The viral production was inhibited at 8-12 hours but was not significant after 24 hours of infection. Therefore, it must be used early in infection based on these in vitro and animal studies https://science.sciencemag.org/content/sci/early/2021/01/22/science.abf4058.full.pdf. Recently modeling efforts and in vitro cell culture studies have examined repurposing other FDA approved drugs as antivirals to treat COVID. These include the old anti-tapeworm drug niclosamide. It has shown broad efficacy against viruses including SARS-CoV-2. This salicylanilide’s antiviral activity is based on its ability to prevent acidification of endocytotic compartments, blocking membrane fusion and infection of the host cell. Early viral studies showed that the efficacy of salicylanilides was derived from the anilide ring, the important role of the N− H group in shuttling protons into the endosome. Niclosamide’s reduction of infection in cells without interacting directly with any viral components presents the possibility of anti-COVID-19 therapeutics with broad activity against current and future variants of the virus, but also may dilute out its effectiveness as seen with antihelmintics like ivermectin and increase the possibility of side effects (Steven Blake et al., Salicylanilides Reduce SARS-CoV‐2 Replication and Suppress Induction of Inflammatory Cytokines in a Rodent Model, https://doi.org/10.1021/acsinfecdis.1c00253
A, ACS Infect. Dis.).
How do we reconcile broad-spectrum, non-specific treatments to counter natural selection of viruses resistant to specific antibody or cellular immunity against requirements to avoid off-target and diluted-out effects of non-specific treatments ? First, the current vaccines may induce broader coverage immunity than illustrated by monoclonal antibody or convalescent plasma responses to infection. Even the difference between male and female immune responses, females having more effective T cell cellular immune responses than males’ B cell dominated antibody response, indicates broader immune coverage from the same SARS-CoV-2 antigens https://science.sciencemag.org/content/sci/371/6527/347.full.pdf. The Th17 response to COVID-19 also indicates a more generalized polyclonal immune response. So don’t write off the current vaccines yet. Second, I have alluded to, in earlier posts, that aptamers which can be selected synthetically to many targets on the virus and be changed rapidly, can also link these anti-ligands to specific pre-existing antibody or immune cells to rapidly mobilize the immune system against the virus and even convert the pathogenic virus into an autogenous endogenous vaccine after directly neutralizing it. The original route of administration was by inhalation to enable self-application of the treatment/prevention. However, these approaches are yet to get out of the basic research laboratory.






HeLa-NR1cells producing and extruding biosynthetic clusters of polymer nanoparticles (white) capable of carrying cell-synthesized RNA